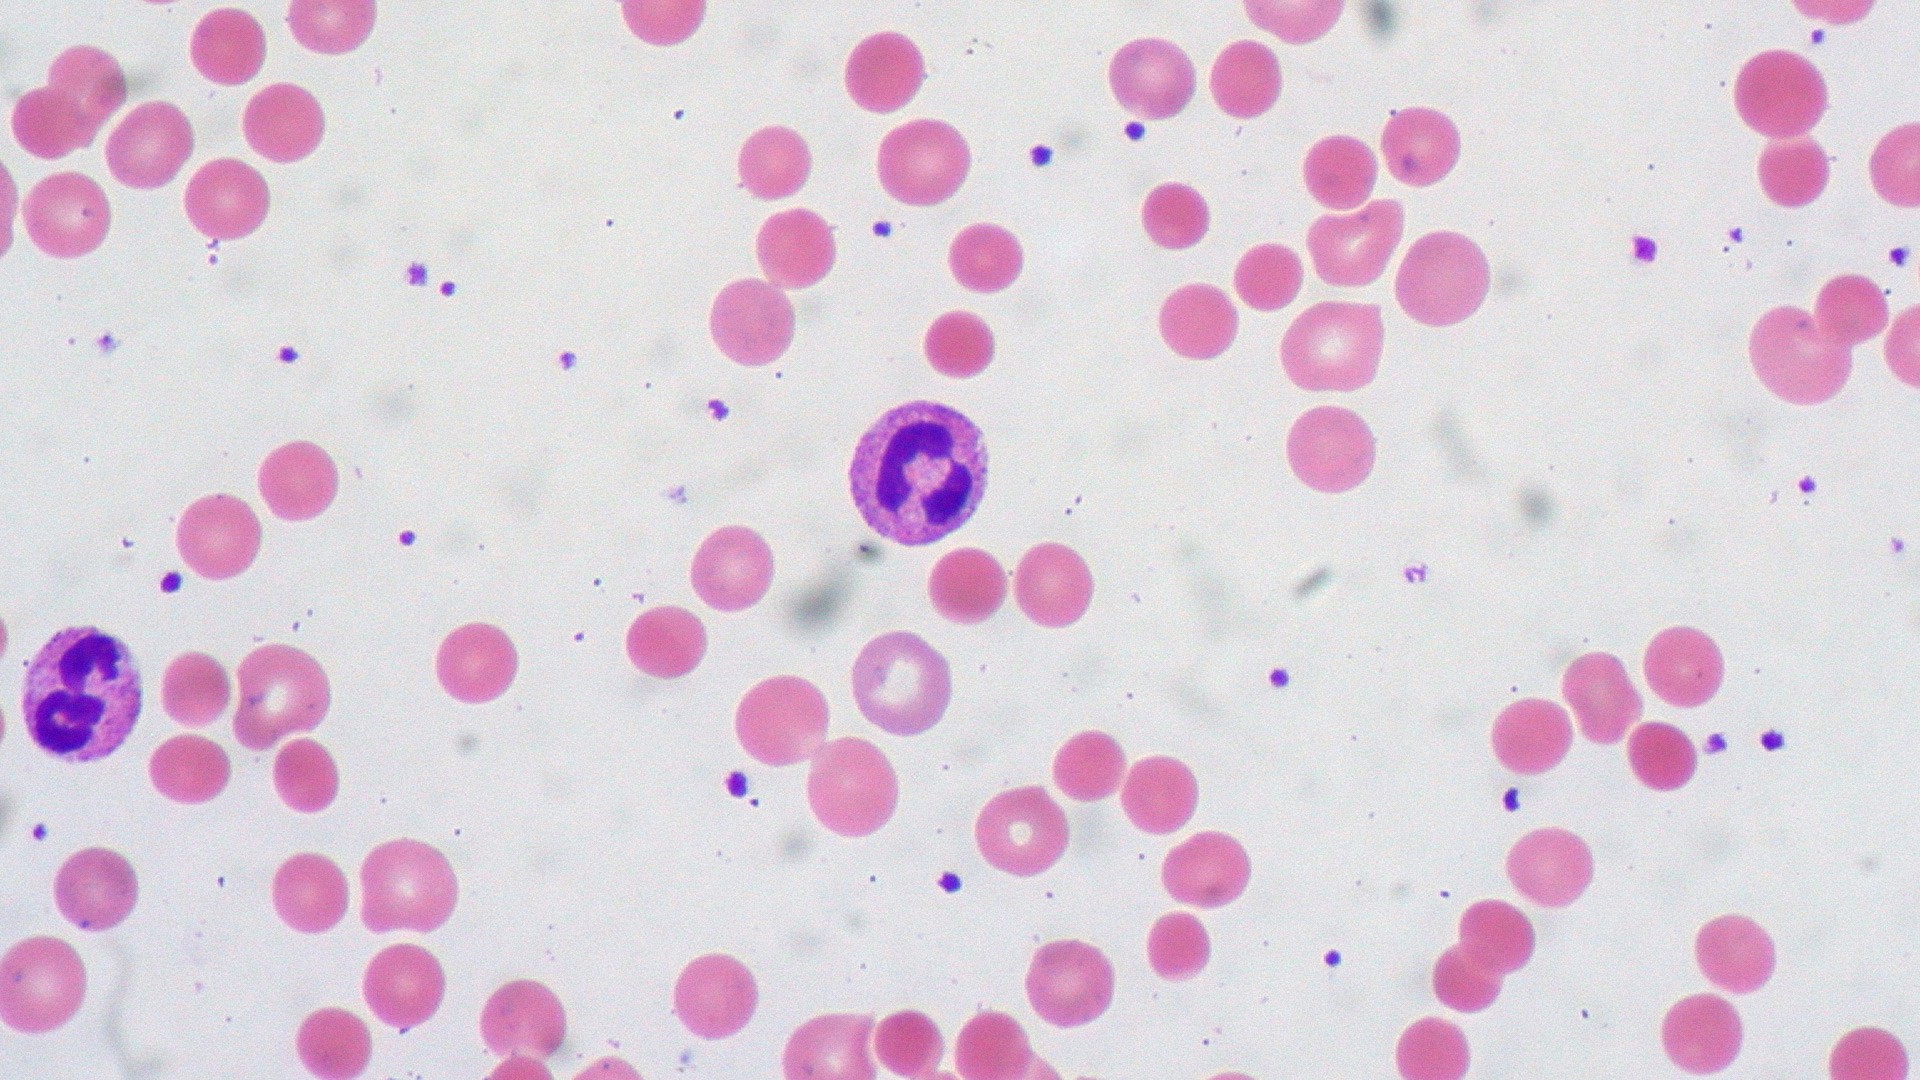

Это аутоиммунное
Как ученые поверили, что иммунитет может вредить организму, и начали это лечить
Раздел аутоиммунных заболеваний в современных медицинских справочниках можно назвать одним из самых парадоксальных. Несмотря на то, что против многих из них успешно разрабатываются лекарства, этиология этих болезней до сих пор вызывает вопросы у ученых. Известно, что обширный список недугов почти из ста пунктов, которыми в сумме страдает около пяти процентов людей, вызван антителами, которые атакуют собственный организм. Ученые, стоявшие у истоков теории иммунитета, не верили, что такое вообще возможно, поэтому появление концепции аутоиммунных заболеваний надолго затормозилось. Совместно с биотехнологической компанией BIOCAD мы расскажем, как ученые определили причины аутоиммунных и аутовоспалительных болезней, какие гипотезы существуют относительно механизма их развития, как их лечили раньше, и как лечат сейчас.
Волчанка епископа
В повествовании о чудесном исцелении Эраклио, эпископа из Льежа, датируемом X веком, упоминается загадочная болезнь под названием lupus (дословно — «волк»). По всей видимости, следующие несколько столетий этим словом называли целый спектр заболеваний, имеющих дерматологические проявления. Однако, судя по описанию врачей из парижского госпиталя Сент-Луис, где в начале XIX века была основана ведущая на тот момент школа кожных болезней, признаки lupus — в частности, «центробежная эритема, наблюдаемая редко, обычно проявляется у молодых людей и женщин преимущественно на лице» — хорошо соответствуют диагностическим критериям заболевания, известного нам сейчас как системная красная волчанка.
В международном классификаторе болезней волчанка до сих пор носит имя lupus erythematosus и относится к системным аутоиммунным заболеваниям. Этот класс разнородных по клиническим проявлениям болезней возникает в результате выработки организмом антител против самого себя — так называемых аутоантител, в результате чего поражаются соединительные ткани и самые разные органы. Волчанка далеко не самая распространенная из них. Но, возможно, самая «медийная» — доктор Грегори Хаус из одноименного сериала не раз подозревал ее у своих пациентов.
Как показывает история волчанки, люди страдали аутоиммунными заболеваниями испокон веков, однако наука официально признала существование такого класса заболеваний только в середине XX века. В 1964 году состоялась первая в истории Международная конференция по аутоиммунным заболеваниям, которая «легализовала» множество диагнозов такого рода и окончательно вывела эту область знаний из тени.
Тем не менее, «полная взлетов и падений» история исследований аутоиммунитета началась одновременно с рождением иммунологии — на стыке XIX и XX веков. «Отец иммунитета» Пауль Эрлих, который ввел в обиход понятие иммунного ответа в виде формулы «в организм попадает чужеродный антиген — организм вырабатывает против него антитела», пробовал иммунизировать коз их же эритроцитами и не увидел никаких антител против собственных тканей. Ученый заключил, что тело каким-то образом защищено от развития иммунной реакции на собственные компоненты и в 1901 году сформулировал концепцию horror autotoxicus, что буквально можно перевести как «ужас самоотравления». Впоследствии эта концепция возродилась в виде теории иммунотолерантности, однако из каждого правила есть исключения.
Уже в 1903 году Карл Ландштейнер, который за два года до этого сформулировал теорию групп крови, описал нескольких пациентов, у которых в крови присутствовал так называемый аутогемолизин — при охлаждении этот белок связывал их собственные эритроциты и приводил к их разрушению (гемолизу). Еще несколько экспериментальных подтверждений существования аутоантител поступили от пациентов с заболеванием щитовидной железы. Однако, как это нередко случается, авторитет выдающегося ученого (Эрлиха) перевесил клинические аргументы. И об аутоантителах забыли еще на несколько десятилетий.

Лихорадка черной воды
Термины «аутоиммунность» и «аутоантитело» появились в научных публикациях только в сороковых годах XX века. По-видимому, концепцию аутоиммунитета активно начал использовать Джеймс Гир, в 1946 году описавший случаи заболевания «лихорадкой черной воды» в Южной Африке. Фактически это состояние представляет собой осложнение рецидива малярии, при котором происходит массовое разрушение эритроцитов (гемолиз). Укреплению позиций этой теории предшествовала серия статей о вакцинах, опубликованных несколькими годами ранее.
Исследователи обнаружили, что пастеровская вакцина против бешенства при многократном введении кроликам иногда вызывает у них острое воспаление мозга — энцефаломиелит. Дело в том, что вакцина, изобретенная Пастером еще в конце XIX века, представляла собой экстракт высушенного спинного мозга кролика, зараженного бешенством. Тогда же ученые показали, что иммунизация кроликов экстрактом кроличьей почки может вызывать у животных нефротоксическое воспаление. Эти эксперименты заставили научную общественность признать, что «ужас самоотравления» — «феномен скорее нефизиологичный, чем невозможный».
В том же 1946 году в экспериментах с человеческим резус-фактором (белком на поверхности эритоцитов) было выделено человеческое антитело, способное связывать красные кровяные клетки и приводить к гемолизу. Гемолитическая анемия стала первым заболеванием, получившим официальное название «аутоиммунное». Однако более важной вехой в этой области медицины стало открытие в пятидесятых годах прошлого века природы болезней щитовидной железы.
Американские ученые Эрнест Витебски и Ноэль Роуз занимались исследованиями тиреоглобулина — основного белка щитовидной железы, необходимого для синтеза тироидных гормонов. На тот момент Витебски, которого называли «наследником мантии Эрлиха», был убежденным сторонником концепции horror autotoxicus. Исследователи выделяли тиреоглобулин кроликов и иммунизировали то же самое или других животных с использованием адъюванта (усилителя иммуногенности). Они обнаружили, что после этого ткань щитовидной железы кроликов напоминает щитовидную железу людей с болезнью Хашимото, которая входит в число наиболее распространенных аутоиммуных заболеваний. Это наблюдение привело к закономерному обнаружению антител против тиреоглобулина у пациентов.
Собственное открытие заставило Витебски сменить убеждения. В 1957 году он с коллегами опубликовал статью, содержащую критерии аутоиммунных заболеваний («постулаты Витебски»). В 1993 году его соратник Роуз дополнил постулаты с учетом новых знаний в области иммунологии. Эти критерии (которые касаются не клинической диагностики, а признания аутоиммунной природы заболевания) требуют прямого доказательства путем переноса патогенного антитела или Т-лимфоцитов, косвенного доказательства путем воспроизведения модели заболевания на животных. Кроме того, они допускают характеристику болезни на основании клинических случаев, к которым относятся, например, ассоциация с другими аутоиммунными заболеваниями и положительный ответ на иммуносупрессию.